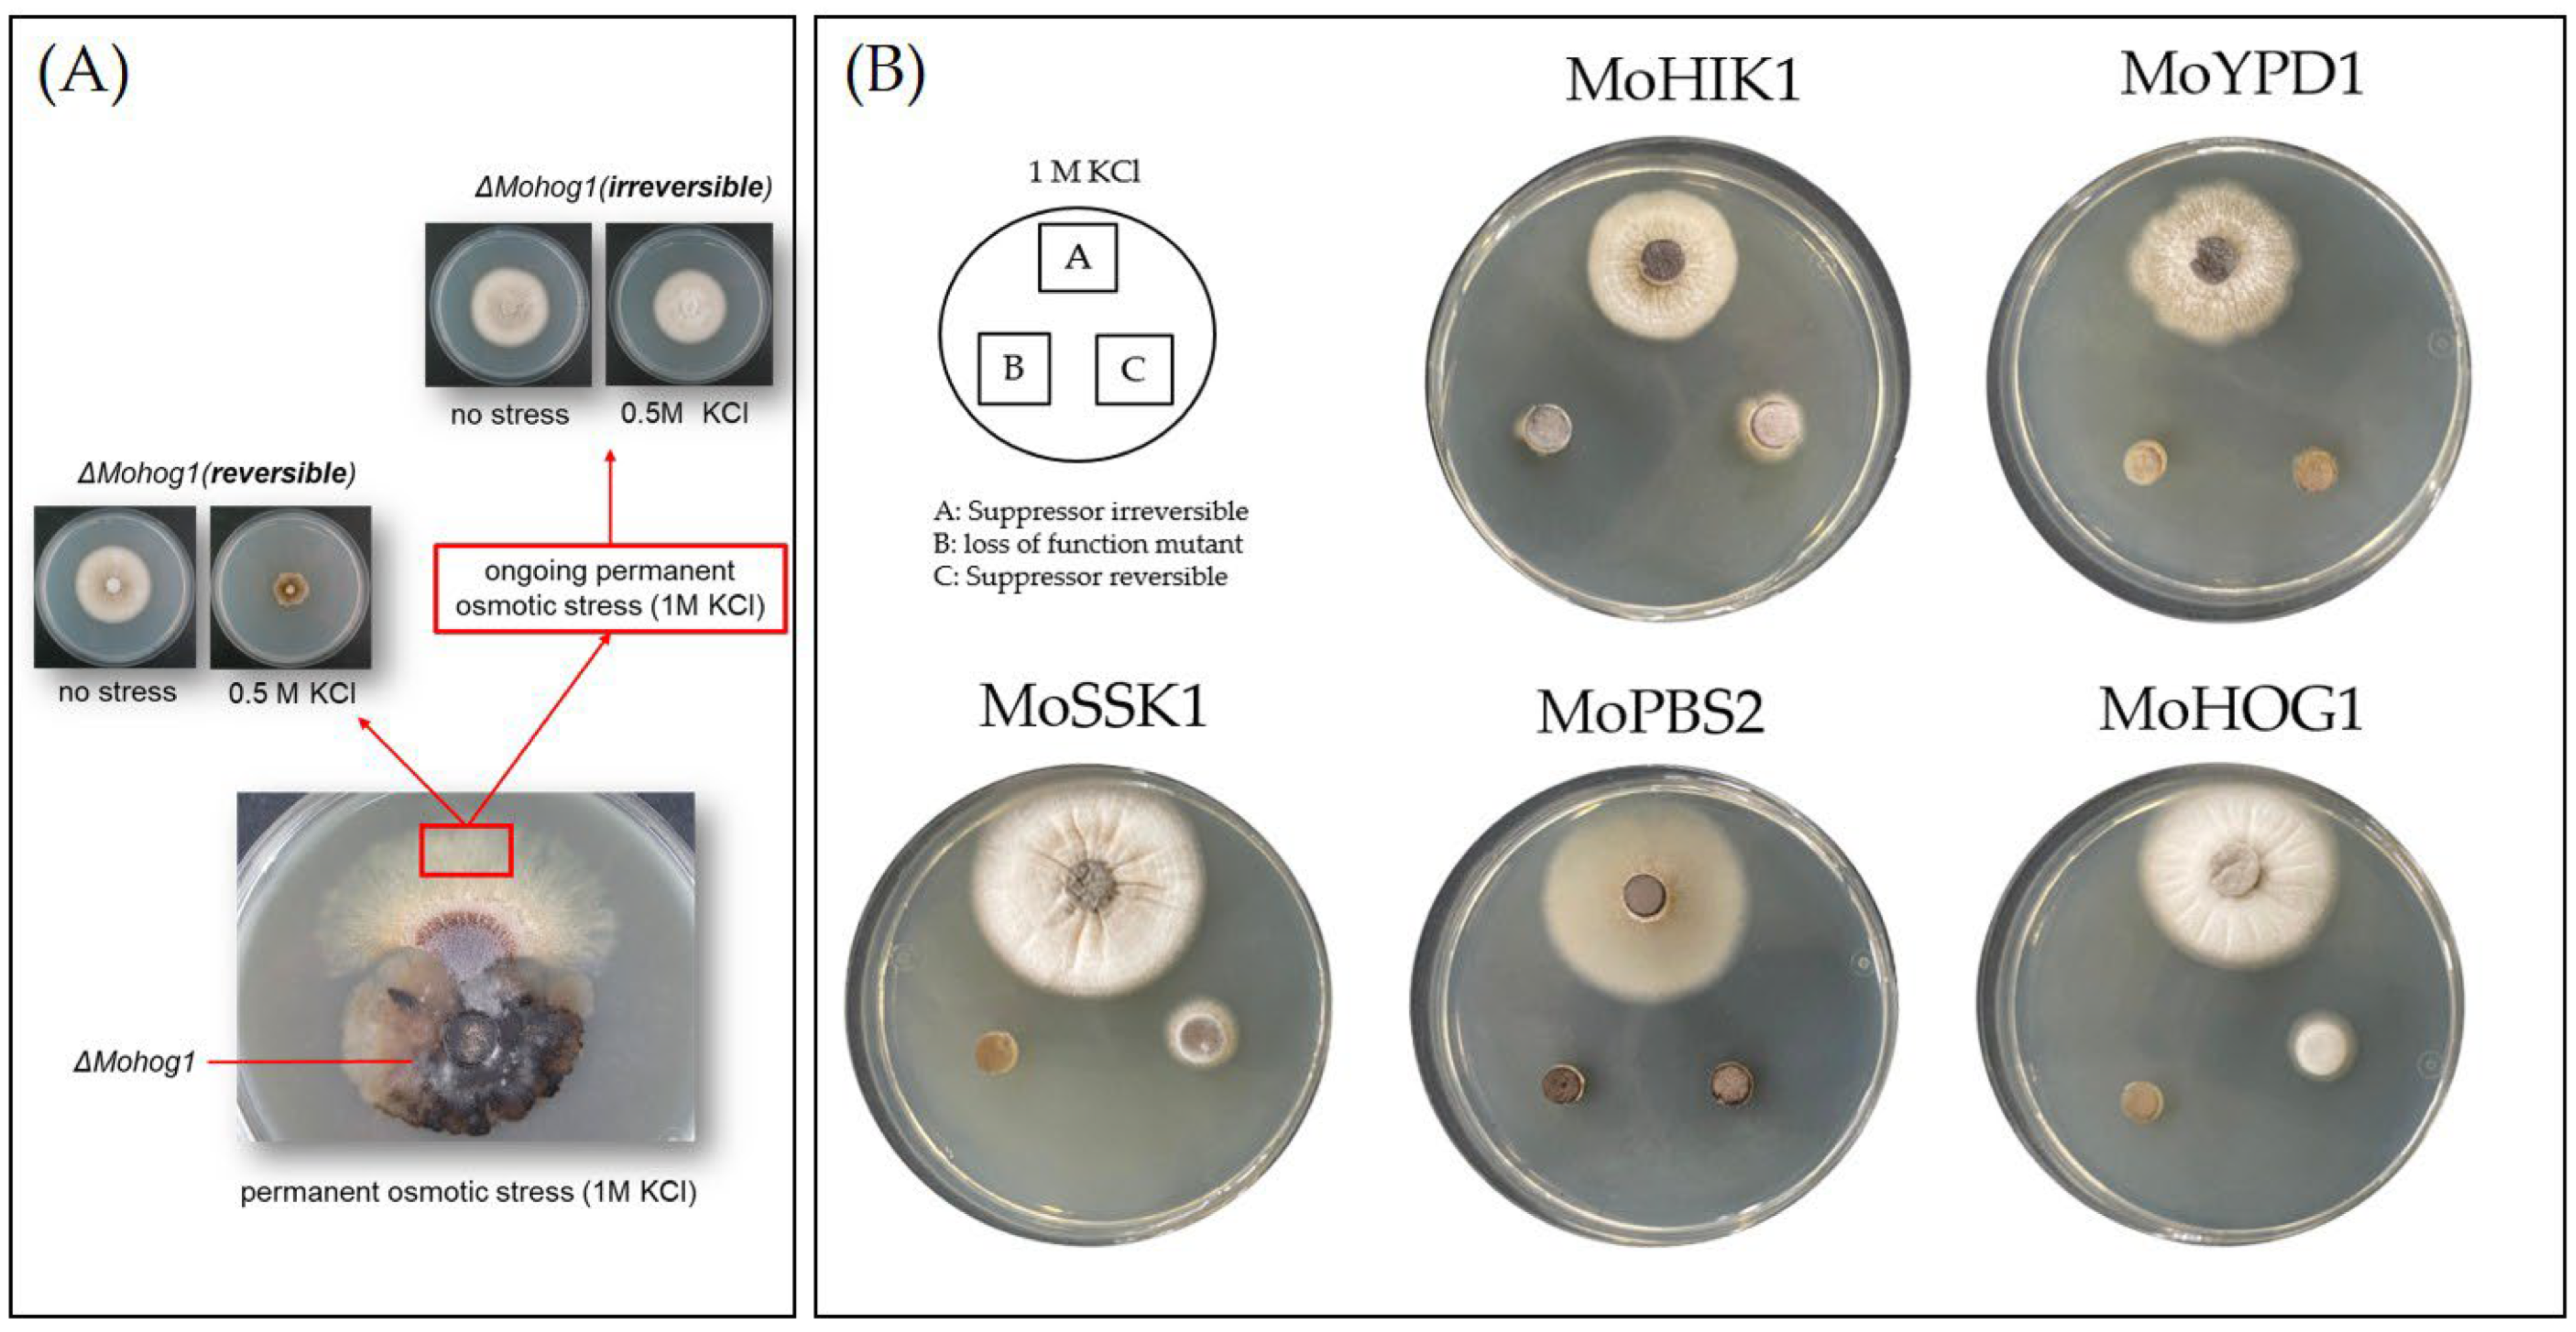
Biology 14 01545 g001 Biology 14 01545 g001
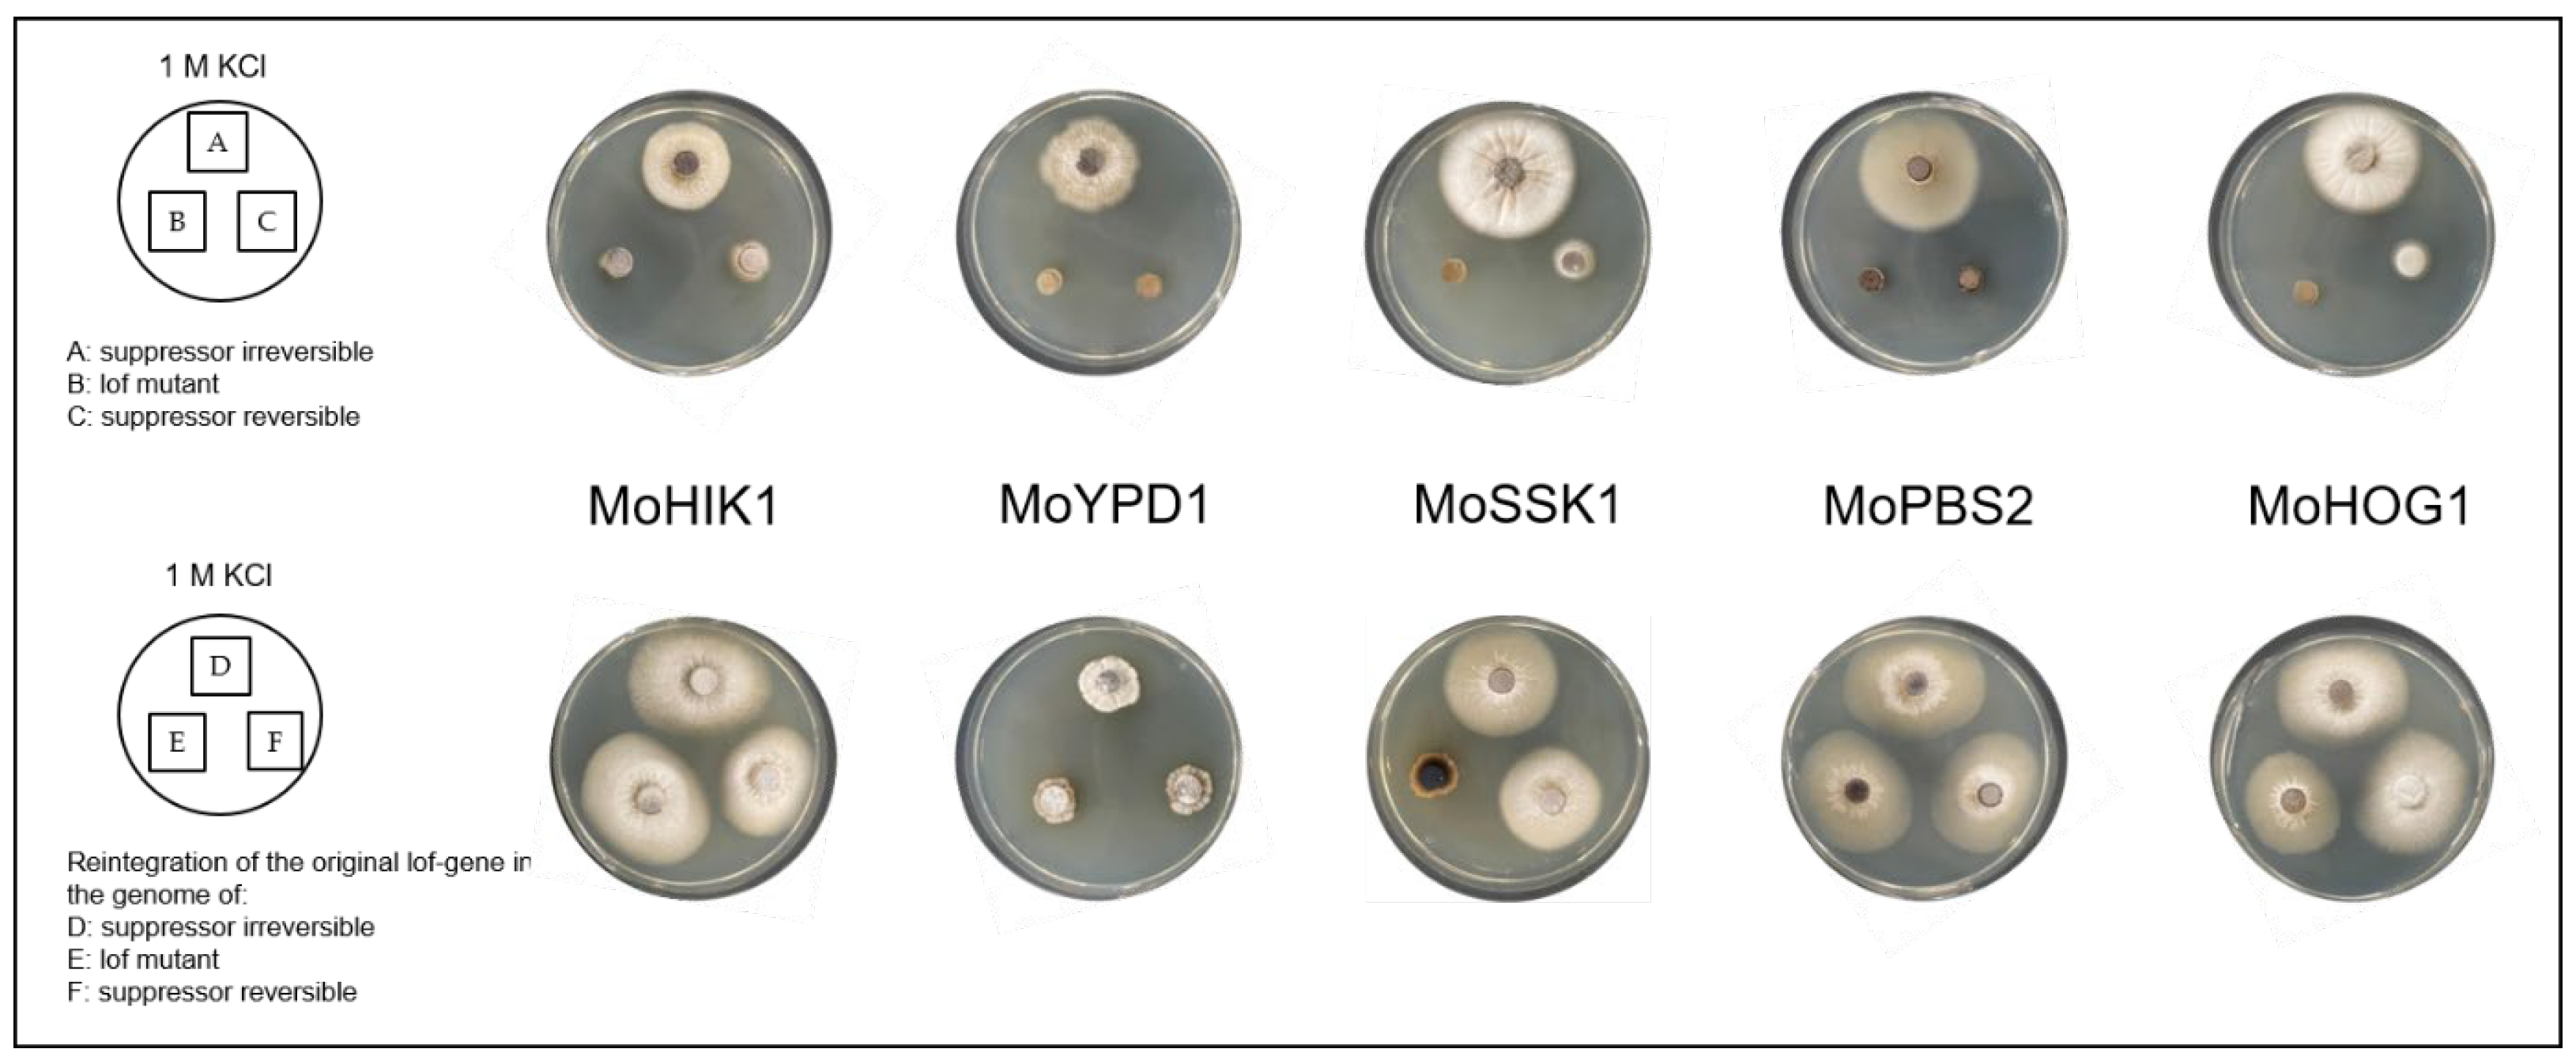
Biology 14 01545 g005 Biology 14 01545 g005

Directed Experimental Adaptive Evolution of Osmoregulation in Fungal Pathogen Magnaporthe oryzae Is Independent of Glycerol Metabolism-Associated Genes
Simple Summary
Abstract
1. Introduction
2. Materials and Methods
2.1. Cultivation of Magnaporthe oryzae
2.2. Single Spore Isolation
2.3. Construct of Vectors for Genetic Manipulation
2.4. Plant Infection Assays
2.5. Vegetative Growth Assays
2.6. Germination Assay
2.7. HPAEC-PAD Analysis to Quantify Compatible Solute Production
2.8. Data Statistics and Analysis
3. Results
3.1. Directed Experimental Adaptive Evolution Results in Two Distinct Types of Suppressors
3.2. The Inactivated HOG Pathway Is the Key Location for Directed Experimental Adaptive Evolution
3.3. Reintegration of Originally HOG Pathway-Inactivated Genes in the Suppressor Strains Restores Naturally Biochemical and Physiological Phenotype
3.4. The Difference of the Biochemical Stress Response in Reversible and Irreversible Suppressor Strains
3.5. Glycerol Metabolism-Associated Genes Are Not the Driving Force for DEA Evolution
4. Discussion
5. Conclusions
Supplementary Materials
Author Contributions
Funding
Institutional Review Board Statement
Informed Consent Statement
Data Availability Statement
Conflicts of Interest
References
- Selmecki, A.M.; Maruvka, Y.E.; Richmond, P.A.; Guillet, M.; Shoresh, N.; Sorenson, A.L.; De, S.; Kishony, R.; Michor, F.; Dowell, R.; et al. Polyploidy Can Drive Rapid Adaptation in Yeast. Nature 2015, 519, 349–352. [Google Scholar] [CrossRef] [PubMed]
- Gladieux, P.; Ropars, J.; Badouin, H.; Branca, A.; Aguileta, G.; de Vienne, D.M.; Rodríguez de la Vega, R.C.; Branco, S.; Giraud, T. Fungal evolutionary genomics provides insight into the mechanisms of adaptive divergence in eukaryotes. Mol. Ecol. 2014, 23, 753–773. [Google Scholar] [CrossRef] [PubMed]
- Card, K.J.; Thomas, M.D.; Grave, J.L., Jr.; Barrick, J.E.; Lenski, R.E. Genomic evolution of antibiotic resistance is contingent on genetic background following a long-term experiment with Escherichia coli. Proc. Natl. Acad. Sci. USA 2021, 118, e2016886118. [Google Scholar] [CrossRef] [PubMed]
- Good, B.H.; McDonald, M.J.; Barrick, J.E.; Lenski, R.E.; Desai, M.M. The Dynamics of Molecular Evolution over 60,000 Generations. Nature 2017, 551, 45–50. [Google Scholar] [CrossRef]
- Covo, S. Genomic instability in fungal plant pathogens. Genes 2020, 11, 421. [Google Scholar] [CrossRef]
- Fouché, S.; Badet, T.; Oggenfuss, U.; Plissonneau, C.; Francisco, C.S.; Croll, D. Stress-Driven Transposable Element De-Repression Dynamics and Virulence Evolution in a Fungal Pathogen. Mol. Biol. Evol. 2020, 37, 221–239. [Google Scholar] [CrossRef]
- Huang, J.; Si, W.; Deng, Q.; Li, P.; Yang, S. Rapid Evolution of Avirulence Genes in Rice Blast Fungus Magnaporthe oryzae. BMC Genet. 2014, 15, 45. [Google Scholar] [CrossRef]
- Naranjo-Ortiz, M.A.; Gabaldón, T. Fungal evolution: Cellular, genomic and metabolic complexity. Biol. Rev. 2020, 95, 1198–1232. [Google Scholar] [CrossRef]
- Wang, Y.; Yang, N.; Zheng, Y.; Yue, J.; Bhadauria, V.; Peng, Y.-L.; Chen, Q. Ubiquitination in the Rice Blast Fungus Magnaporthe oryzae: From Development and Pathogenicity to Stress Responses. Phytopathol. Res. 2022, 4, 1. [Google Scholar] [CrossRef]
- Sutthiphai, T.; Damchuay, K.; Neupane, R.C.; Longya, A.; Sriwongchai, T.; Songkumarn, P.; Parinthawong, N.; Darwell, K.; Jantasuriyarat, C. Genetic Variation of Avirulence Genes (AVR-Pi9, AVR-Pik, AVR-Pita1) and Genetic Diversity of Rice Blast Fungus, Pyricularia Oryzae, in Thailand. Plant Pathol. 2022, 71, 322–333. [Google Scholar] [CrossRef]
- Jacob, S.; Bühring, S.; Bersching, K. Recent Advances in Research on Molecular Mechanisms of Fungal Signaling. Encyclopedia 2022, 2, 840–863. [Google Scholar] [CrossRef]
- Scheuerl, T.; Hopkins, M.; Nowell, R.W.; Rivett, D.W.; Barraclough, T.G.; Bell, T. Bacterial Adaptation Is Constrained in Complex Communities. Nat. Commun. 2020, 11, 754. [Google Scholar] [CrossRef] [PubMed]
- Jacob, S.; Foster, A.J.; Yemelin, A.; Thines, E. High Osmolarity Glycerol (HOG) Signalling in Magnaporthe oryzae: Identification of MoYPD1 and Its Role in Osmoregulation, Fungicide Action, and Pathogenicity. Fungal Biol. 2015, 119, 580–594. [Google Scholar] [CrossRef] [PubMed]
- Jacob, S.; Bersching, K. Controllable Bypass Suppression in Magnaporthe Oryzae. In Magnaporthe oryzae: Methods and Protocols; Jacob, S., Ed.; Methods in Molecular Biology; Springer: New York, NY, USA, 2021; pp. 225–231. ISBN 978-1-07-161613-0. [Google Scholar]
- Hohmann, S. Control of high osmolarity signalling in the yeast Saccharomyces cerevisiae. FEBS Lett. 2009, 583, 4025–4029. [Google Scholar] [CrossRef]
- Jacob, S.; Schüffler, A.; Thines, E. Hog1p Activation by Marasmic Acid through Inhibition of the Histidine Kinase Sln1p. Pest Manag. Sci. 2016, 72, 1268–1274. [Google Scholar] [CrossRef]
- Dixon, K.P.; Xu, J.R.; Smirnoff, N.; Talbot, N.J. Independent signaling pathways regulate cellular turgor during hyperosmotic stress and appressorium-mediated plant infection by Magnaporthe grisea. Plant Cell 1999, 11, 2045–2058. [Google Scholar] [CrossRef]
- Bohnert, S.; Antelo, L.; Grünewald, C.; Yemelin, A.; Andresen, K.; Jacob, S. Rapid Adaptation of Signaling Networks in the Fungal Pathogen Magnaporthe oryzae. BMC Genom. 2019, 20, 763. [Google Scholar] [CrossRef]
- Bohnert, S.; Neumann, H.; Thines, E.; Jacob, S. Visualizing fungicide action: An in vivo tool for rapid validation of fungicides with target location HOG pathway. Pest Manag. Sci. 2019, 75, 772–778. [Google Scholar] [CrossRef]
- de Groot, M.J.A.; Bundock, P.; Hooykaas, P.J.J.; Beijersbergen, A.G.M. Agrobacterium Tumefaciens -Mediated Transformation of Filamentous Fungi. Nat. Biotechnol. 1998, 16, 839–842. [Google Scholar] [CrossRef]
- Rho, H.-S.; Kang, S.; Lee, Y.H. Agrobacterium Tumefaciens-Mediated Transformation of the Plant Pathogenic Fungus, Magnaporthe Grisea. Mol. Cells 2001, 12, 407–411. [Google Scholar] [CrossRef]
- Odenbach, D.; Breth, B.; Thines, E.; Weber, R.W.S.; Anke, H.; Foster, A.J. The Transcription Factor Con7p Is a Central Regulator of Infection-Related Morphogenesis in the Rice Blast Fungus Magnaporthe Grisea. Mol. Microbiol. 2007, 64, 293–307. [Google Scholar] [CrossRef]
- Jacob, S.; Foster, A.J.; Yemelin, A.; Thines, E. Histidine kinases mediate differentiation, stress response, and pathogenicity in Magnaporthe oryzae. Microbiologyopen 2014, 3, 668–687. [Google Scholar] [CrossRef]
- Grünewald, C.; Bohnert, S.; Jacob, S. The determination of carbohydrates by high-performance anion-exchange chromatography coupled with pulsed amperometric detection (HPAEC-PAD). In Magnaporthe oryzae: Methods and Protocols; Springer: New York, NY, USA, 2021; pp. 57–68. [Google Scholar]
- Pires-da Silva, A.; Sommer, R.J. The evolution of signalling pathways in animal development. Nat. Rev. Genet. 2003, 4, 39–49. [Google Scholar] [CrossRef]
- McDonald Michael, J. Microbial experimental evolution—A proving ground for evolutionary theory and a tool for discovery. EMBO Rep. 2019, 20, e46992. [Google Scholar] [CrossRef] [PubMed]
- Lenski, R.E. Experimental evolution and the dynamics of adaptation and genome evolution in microbial populations. ISME J. 2017, 11, 2181–2194. [Google Scholar] [CrossRef] [PubMed]
- Lenski, R.E.; Rose, M.R.; Simpson, S.C.; Tadler, S.C. Long-term experimental evolution in Escherichia-coli. I. Adaptation and divergence during 2000 generations. Am. Nat. 1991, 138, 1315–1341. [Google Scholar] [CrossRef]
- Kanehisa, M. Toward understanding the origin and evolution of cellular organisms. Protein Sci. 2019, 28, 1947–1951. [Google Scholar] [CrossRef]
- Shi, Y.; Wang, H.; Yan, Y.; Cao, H.; Liu, X.; Lin, F.; Lu, J. Glycerol-3-phosphate shuttle is involved in development and virulence in the rice blast fungus Pyricularia oryzae. Front. Plant Sci. 2018, 9, 687. [Google Scholar] [CrossRef]
- Frieri, M.; Kumar, K.; Boutin, A. Antibiotic Resistance. J. Infect. Public Health 2017, 10, 369–378. [Google Scholar] [CrossRef]

Disclaimer/Publisher’s Note: The statements, opinions and data contained in all publications are solely those of the individual author(s) and contributor(s) and not of MDPI and/or the editor(s). MDPI and/or the editor(s) disclaim responsibility for any injury to people or property resulting from any ideas, methods, instructions or products referred to in the content. |
© 2025 by the authors. Licensee MDPI, Basel, Switzerland. This article is an open access article distributed under the terms and conditions of the Creative Commons Attribution (CC BY) license (https://creativecommons.org/licenses/by/4.0/).
Share and Cite
Bersching, K.; Grünewald, C.; Jacob, S. Directed Experimental Adaptive Evolution of Osmoregulation in Fungal Pathogen Magnaporthe oryzae Is Independent of Glycerol Metabolism-Associated Genes. Biology 2025, 14, 1545. https://doi.org/10.3390/biology14111545
Bersching K, Grünewald C, Jacob S. Directed Experimental Adaptive Evolution of Osmoregulation in Fungal Pathogen Magnaporthe oryzae Is Independent of Glycerol Metabolism-Associated Genes. Biology. 2025; 14(11):1545. https://doi.org/10.3390/biology14111545
Chicago/Turabian StyleBersching, Katharina, Christiane Grünewald, and Stefan Jacob. 2025. "Directed Experimental Adaptive Evolution of Osmoregulation in Fungal Pathogen Magnaporthe oryzae Is Independent of Glycerol Metabolism-Associated Genes" Biology 14, no. 11: 1545. https://doi.org/10.3390/biology14111545
APA StyleBersching, K., Grünewald, C., & Jacob, S. (2025). Directed Experimental Adaptive Evolution of Osmoregulation in Fungal Pathogen Magnaporthe oryzae Is Independent of Glycerol Metabolism-Associated Genes. Biology, 14(11), 1545. https://doi.org/10.3390/biology14111545

